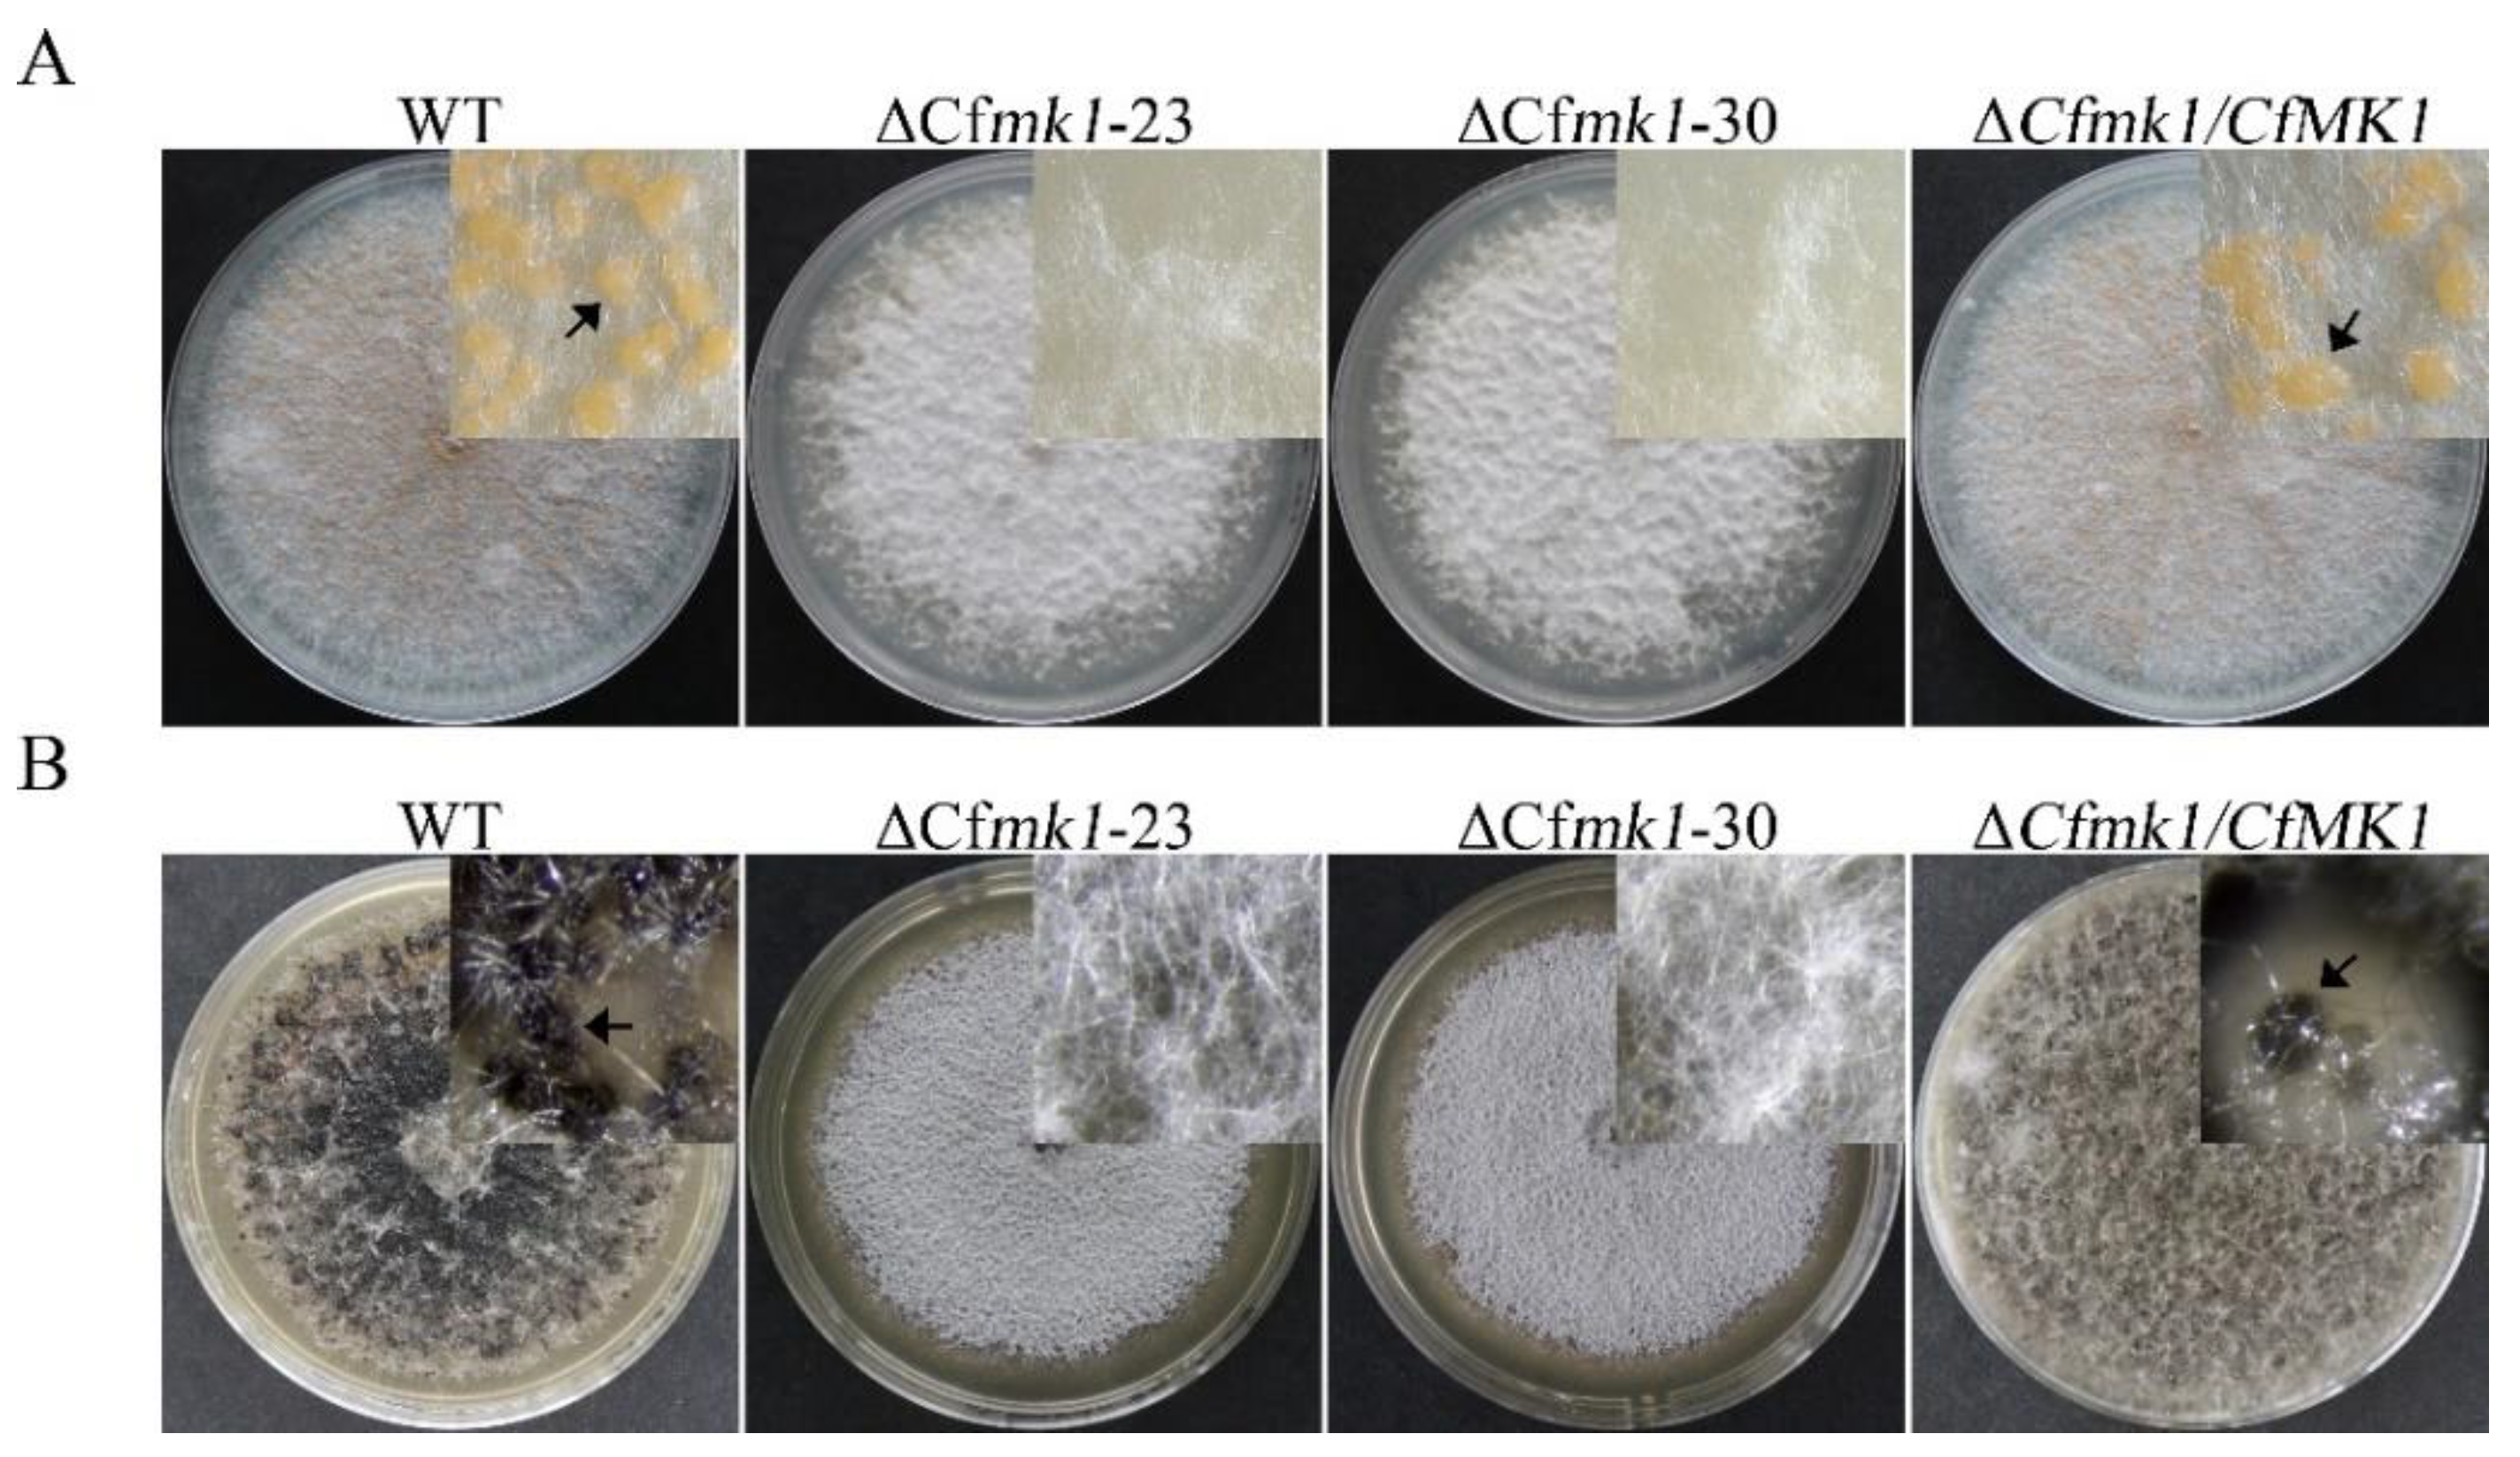
Jof 08 00077 g002

The CfMK1 Gene Regulates Reproduction, Appressorium Formation, and Pathogenesis in a Pear Anthracnose-Causing Fungus
Abstract
1. Introduction
2. Materials and Methods
2.1. Fungal Strains and Culture Conditions
2.2. Generation of the Cfmk1 Deletion Mutants
2.3. Generation of the CfMK1-GFP Fusion Construct
2.4. Appressorium Formation, Penetration and Plant Infection Assays
2.5. RNA-Seq Analysis
3. Results
3.1. Identification and Deletion of CfMK1
3.2. CfMK1 Deletion Affects Aerial Hyphal Growth
3.3. CfMK1 Is Required for Asexual and Sexual Reproduction on Solid Medium but Is Not Necessary for Conidiogenesis in Liquid Medium
3.4. CfMK1 Is Required for Cell Wall Integrity
3.5. CfMK1 Is Required for Conidial Germination and Appressorium Formation
3.6. CfMK1 Is Essential for Plant Penetration
3.7. CfMK1 Is Necessary for Full Virulence on Pear Leaves and Fruit
3.8. Complementation and Localization of CfMK1
3.9. CfMK1 Deletion Affects the Expression of Different Subsets of Genes in C. fructicola
4. Discussion
Supplementary Materials
Author Contributions
Funding
Institutional Review Board Statement
Informed Consent Statement
Data Availability Statement
Acknowledgments
Conflicts of Interest
References
- Wu, J.; Wang, Z.; Shi, Z.; Zhang, S.; Ming, R.; Zhu, S.; Khan, M.A.; Tao, S.; Korban, S.S.; Wang, H.; et al. The genome of the pear (Pyrus bretschneideri Rehd.). Genome Res. 2013, 23, 396–408. [Google Scholar] [CrossRef]
- Nobuya, T.; Ide, Y.; Noguchi, M.; Watanabe, H.; Nita, M. Emergence of Benzimidazole- and Strobilurin-Quinone Outside Inhibitor-Resistant Strains of Colletotrichum gloeosporioides sensu lato, the Causal Fungus of Japanese Pear Anthracnose, and Alternative Fungicides to Resistant Strains. In Plant Diseases; Topolovec-Pintarić, S., Ed.; IntechOpen: Rijeka, Croatia, 2020. [Google Scholar]
- Kim, W.G.; Hong, S.K.; Park, Y.S. Occurrence of Anthracnose on Fruits of Asian Pear Tree Caused by Colletotrichum acutatum. Mycobiology 2007, 35, 238–240. [Google Scholar] [CrossRef]
- Li, H.N.; Jiang, J.J.; Hong, N.; Wang, G.P.; Xu, W.X. First Report of Colletotrichum fructicola causing bitter rot of pear (Pyrus bretschneideri) in China. Plant Dis. 2013, 97, 1000. [Google Scholar] [CrossRef]
- Zhang, P.F.; Zhai, L.F.; Zhang, X.K.; Huang, X.Z.; Hong, N.; Xu, W.; Wang, G. Characterization of Colletotrichum fructicola, a new causal agent of leaf black spot disease of sandy pear (Pyrus pyrifolia). Eur. J. Plant Pathol. 2015, 143, 651–662. [Google Scholar] [CrossRef]
- Li, C.; Tang, B.; Cao, S.; Bao, Y.; Sun, W.; Zhao, Y.; Liu, F. Biocontrol ability and action mechanism of dihydromaltophilin against Colletotrichum fructicola causing anthracnose of pear fruit. Pest Manag. Sci. 2021, 77, 1061–1069. [Google Scholar] [CrossRef]
- Jiang, J.; Zhai, H.; Li, H.; Wang, Z.; Chen, Y.; Hong, N.; Wang, G.; Chofong, G.N.; Xu, W. Identification and characterization of Colletotrichum fructicola causing black spots on young fruits related to bitter rot of pear (Pyrus bretschneideri Rehd.) in China. Crop Prot. 2014, 58, 41–48. [Google Scholar] [CrossRef]
- Fu, M.; Crous, P.W.; Bai, Q.; Zhang, P.; Xiang, J.; Yashuang, G.; Zhao, F.; Yang, M.; Hong, N.; Xu, W.; et al. Colletotrichum species associated with anthracnose of Pyrus spp. in China. Pers. Mol. Phylogeny Evol. Fungi 2018, 42, 1–35. [Google Scholar] [CrossRef] [PubMed]
- Lev, S.; Sharon, A.; Hadar, R.; Ma, H.; Horwitz, B.A. A mitogen-activated protein kinase of the corn leaf pathogen Cochliobolus heterostrophus is involved in conidiation, appressorium formation, and pathogenicity: Diverse roles for mitogen-activated protein kinase homologs in foliar pathogens. Proc. Natl. Acad. Sci. USA 1999, 96, 13542–13547. [Google Scholar] [CrossRef] [PubMed]
- Cannon, P.F.; Damm, U.; Johnston, P.R.; Weir, B.S. Colletotrichum—Current status and future directions. Stud. Mycol. 2012, 73, 181–213. [Google Scholar] [CrossRef] [PubMed]
- Errede, B.; Gartner, A.; Zhou, Z.; Nasmyth, K.; Ammerer, G. MAP kinase-related FUS3 from S. cerevisiae is activated by STE7 in vitro. Nature 1993, 362, 261–264. [Google Scholar] [CrossRef] [PubMed]
- Xu, J.R.; Hamer, J.E. MAP kinase and cAMP signaling regulate infection structure formation and pathogenic growth in the rice blast fungus Magnaporthe grisea. Genes Dev. 1996, 10, 2696–2706. [Google Scholar] [CrossRef]
- Zhang, Y.; Ge, Q.; Cao, Q.; Cui, H.; Hu, P.; Yu, X.; Ye, Z. Cloning and characterization of two MAPK genes UeKpp2 and UeKpp6 in Ustilago esculenta. Curr. Microbiol. 2018, 75, 1016–1024. [Google Scholar] [CrossRef] [PubMed]
- He, P.; Wang, Y.; Wang, X.; Zhang, X.; Tian, C. The mitogen-activated protein kinase CgMK1 governs appressorium formation, melanin synthesis, and plant infection of Colletotrichum gloeosporioides. Front. Microbiol. 2017, 8, 2216. [Google Scholar] [CrossRef] [PubMed]
- Yu, L.; Xiong, D.; Han, Z.; Liang, Y.; Tian, C. The mitogen-activated protein kinase gene CcPmk1 is required for fungal growth, cell wall integrity and pathogenicity in Cytospora chrysosperma. Fungal Genet. Biol. 2019, 128, 1–13. [Google Scholar] [CrossRef] [PubMed]
- Wu, Y.; Xu, L.; Liu, J.; Yin, Z.; Gao, X.; Feng, H.; Huang, L. A mitogen-activated protein kinase gene (VmPmk1) regulates virulence and cell wall degrading enzyme expression in Valsa mali. Microb. Pathog. 2017, 111, 298–306. [Google Scholar] [CrossRef] [PubMed]
- Segorbe, D.; Di Pietro, A.; Pérez-Nadales, E.; Turrà, D. Three Fusarium oxysporum mitogen-activated protein kinases (MAPKs) have distinct and complementary roles in stress adaptation and cross-kingdom pathogenicity. Mol. Plant Pathol. 2017, 18, 912–924. [Google Scholar] [CrossRef]
- Cho, Y.; Cramer, R.A., Jr.; Kim, K.H.; Davis, J.; Mitchell, T.K.; Figuli, P.; Pryor, B.M.; Lemasters, E.; Lawrence, C.B. The Fus3/Kss1 MAP kinase homolog Amk1 regulates the expression of genes encoding hydrolytic enzymes in Alternaria brassicicola. Fungal Genet. Biol. 2007, 44, 543–553. [Google Scholar] [CrossRef]
- Jiang, C.; Zhang, X.; Liu, H.; Xu, J.R. Mitogen-activated protein kinase signaling in plant pathogenic fungi. PLoS Pathog. 2018, 14, e1006875. [Google Scholar] [CrossRef]
- Pareek, M.; Rajam, M.V. RNAi-mediated silencing of MAP kinase signalling genes (Fmk1, Hog1, and Pbs2) in Fusarium oxysporum reduces pathogenesis on tomato plants. Fungal Biol. 2017, 121, 775–784. [Google Scholar] [CrossRef]
- Spada, M.; Pugliesi, C.; Fambrini, M.; Pecchia, S. Silencing of the Slt2-type MAP kinase Bmp3 in Botrytis cinerea by application of exogenous dsRNA affects fungal growth and virulence on Lactuca sativa. Int. J. Mol. Sci. 2021, 22, 5362. [Google Scholar] [CrossRef]
- Yamauchi, J.; Takayanagi, N.; Komeda, K.; Takano, Y.; Okuno, T. cAMP-PKA signaling regulates multiple steps of fungal infection cooperatively with Cmk1 MAP kinase in Colletotrichum lagenarium. Mol. Plant-Microbe Interact. 2004, 17, 1355–1365. [Google Scholar] [CrossRef][Green Version]
- Wei, W.; Xiong, Y.; Zhu, W.; Wang, N.; Yang, G.; Peng, F. Colletotrichum higginsianum mitogen-activated protein kinase ChMK1: Role in growth, cell wall integrity, colony melanization, and pathogenicity. Front. Microbiol. 2016, 7, 1212. [Google Scholar] [CrossRef] [PubMed]
- Xiong, Q.; Xu, J.; Zhao, Y.; Wang, K. CtPMK1, a mitogen-activated-protein kinase gene, is required for conidiation, appressorium formation, and pathogenicity of Colletotrichum truncatum on soybean. Ann. Appl. Biol. 2015, 167, 63–74. [Google Scholar] [CrossRef]
- Jenczmionka, N.J.; Maier, F.J.; Losch, A.P.; Schafer, W. Mating, conidiation and pathogenicity of Fusarium graminearum, the main causal agent of the head-blight disease of wheat, are regulated by the MAP kinase gpmk1. Curr. Genet. 2003, 43, 87–95. [Google Scholar] [CrossRef] [PubMed]
- Zhang, Y.; Choi, Y.E.; Zou, X.; Xu, J.R. The FvMK1 mitogen-activated protein kinase gene regulates conidiation, pathogenesis, and fumonisin production in Fusarium verticillioides. Fungal Genet. Biol. 2011, 48, 71–79. [Google Scholar] [CrossRef] [PubMed]
- Lin, C.-H.; Yang, S.L.; Wang, N.-Y.; Chung, K.-R. The FUS3 MAPK signaling pathway of the citrus pathogen Alternaria alternata functions independently or cooperatively with the fungal redox-responsive AP1 regulator for diverse developmental, physiological and pathogenic processes. Fungal Genet. Biol. 2010, 47, 381–391. [Google Scholar] [CrossRef]
- Armesto, C.; Maia, F.G.; de Abreu, M.S.; Figueira Ados, R.; da Silva, B.M.; Monteiro, F.P. Genetic transformation with the gfp gene of Colletotrichum gloeosporioides isolates from coffee with blister spot. Braz. J. Microbiol. 2012, 43, 1222–1229. [Google Scholar] [CrossRef] [PubMed][Green Version]
- Liu, W.; Liang, X.; Gleason, M.L.; Cao, M.; Zhang, R.; Sun, G. Transcription factor CfSte12 of Colletotrichum fructicola is a key regulator of early apple glomerella leaf spot pathogenesis. Appl. Environ. Microbiol. 2020, 87, e02212-20. [Google Scholar] [CrossRef]
- Catlett, N.; Lee, B.-N.; Yoder, O.; Turgeon, B.G. Split-marker recombination for efficient targeted deletion of fungal genes. Fungal Genet. Newsl. 2003, 50, 9–11. [Google Scholar] [CrossRef]
- Zhou, X.; Li, G.; Xu, J.R. Efficient approaches for generating GFP fusion and epitope-tagging constructs in filamentous fungi. Methods Mol. Biol. 2011, 722, 199–212. [Google Scholar] [CrossRef]
- Li, C.; Cao, S.; Zhang, C.; Zhang, Y.; Zhang, Q.; Xu, J.R.; Wang, C. MoCDC14 is important for septation during conidiation and appressorium formation in Magnaporthe oryzae. Mol. Plant Pathol. 2018, 19, 328–340. [Google Scholar] [CrossRef]
- Yuan, Q.; Yan, Y.; Sohail, M.A.; Liu, H.; Huang, J.; Hsiang, T.; Zheng, L. A novel hexose transporter ChHxt6 is required for hexose uptake and virulence in Colletotrichum higginsianum. Int. J. Mol. Sci. 2021, 22, 5963. [Google Scholar] [CrossRef] [PubMed]
- Zhou, Z.; Wu, J.; Wang, M.; Zhang, J. ABC protein CgABCF2 is required for asexual and sexual development, appressorial formation and plant infection in Colletotrichum gloeosporioides. Microb. Pathog. 2017, 110, 85–92. [Google Scholar] [CrossRef]
- Wang, X.; Lu, D.; Tian, C. CgEnd3 regulates endocytosis, appressorium formation, and virulence in the Poplar Anthracnose fungus Colletotrichum gloeosporioides. Int. J. Mol. Sci. 2021, 22, 4029. [Google Scholar] [CrossRef]
- Gan, P.; Ikeda, K.; Irieda, H.; Narusaka, M.; O’Connell, R.J.; Narusaka, Y.; Takano, Y.; Kubo, Y.; Shirasu, K. Comparative genomic and transcriptomic analyses reveal the hemibiotrophic stage shift of Colletotrichum fungi. New Phytol. 2013, 197, 1236–1249. [Google Scholar] [CrossRef] [PubMed]
- Kim, D.; Langmead, B.; Salzberg, S.L. HISAT: A fast spliced aligner with low memory requirements. Nat. Methods 2015, 12, 357–360. [Google Scholar] [CrossRef] [PubMed]
- Roberts, A.; Trapnell, C.; Donaghey, J.; Rinn, J.L.; Pachter, L. Improving RNA-Seq expression estimates by correcting for fragment bias. Genome Biol. 2011, 12, R22. [Google Scholar] [CrossRef]
- Trapnell, C.; Williams, B.A.; Pertea, G.; Mortazavi, A.; Kwan, G.; van Baren, M.J.; Salzberg, S.L.; Wold, B.J.; Pachter, L. Transcript assembly and quantification by RNA-Seq reveals unannotated transcripts and isoform switching during cell differentiation. Nat. Biotechnol. 2010, 28, 511–515. [Google Scholar] [CrossRef]
- Anders, S.; Pyl, P.T.; Huber, W. HTSeq—A Python framework to work with high-throughput sequencing data. Bioinformatics 2015, 31, 166–169. [Google Scholar] [CrossRef]
- Anders, S.; Huber, W. Differential Expression of RNA-Seq Data at the Gene Level—The DESeq Package; European Molecular Biology Laboratory (EMBL): Heidelberg, Germany, 2012. [Google Scholar]
- Fukada, F.; Kodama, S.; Nishiuchi, T.; Kajikawa, N.; Kubo, Y. Plant pathogenic fungi Colletotrichum and Magnaporthe share a common G1 phase monitoring strategy for proper appressorium development. New Phytol. 2019, 222, 1909–1923. [Google Scholar] [CrossRef]
- Madhani, H.D.; Styles, C.A.; Fink, G.R. MAP kinases with distinct inhibitory functions impart signaling specificity during yeast differentiation. Cell 1997, 91, 673–684. [Google Scholar] [CrossRef]
- Panwar, V.; Jordan, M.; McCallum, B.; Bakkeren, G. Host-induced silencing of essential genes in Puccinia triticina through transgenic expression of RNAi sequences reduces severity of leaf rust infection in wheat. Plant Biotechnol. J. 2018, 16, 1013–1023. [Google Scholar] [CrossRef]
- Garcia-Rubio, R.; de Oliveira, H.C.; Rivera, J.; Trevijano-Contador, N. The fungal cell wall: Candida, Cryptococcus, and Aspergillus species. Front. Microbiol. 2020, 10, 2993. [Google Scholar] [CrossRef]
- Wang, X.; Lu, D.; Tian, C. Mitogen-activated protein kinase cascade CgSte50-Ste11-Ste7-Mk1 regulates infection-related morphogenesis in the poplar anthracnose fungus Colletotrichum gloeosporioides. Microbiol. Res. 2021, 248, 126748. [Google Scholar] [CrossRef]
- Ren, J.; Li, C.; Gao, C.; Xu, J.R.; Jiang, C.; Wang, G. Deletion of FgHOG1 is suppressive to the mgv1 mutant by stimulating Gpmk1 activation and avoiding intracellular turgor elevation in Fusarium graminearum. Front. Microbiol. 2019, 10, 1073. [Google Scholar] [CrossRef]
- Boorsma, A.; de Nobel, H.; ter Riet, B.; Bargmann, B.; Brul, S.; Hellingwerf, K.J.; Klis, F.M. Characterization of the transcriptional response to cell wall stress in Saccharomyces cerevisiae. Yeast 2004, 21, 413–427. [Google Scholar] [CrossRef]
- Magyar, D.; Vass, M.; Li, D.-W. Dispersal Strategies of Microfungi. In Biology of Microfungi; Li, D.W., Ed.; Springer: Cham, Switzerland, 2016; pp. 315–371. [Google Scholar]
- Boualem, K.; Waché, Y.; Garmyn, D.; Karbowiak, T.; Durand, A.; Gervais, P.; Cavin, J.-F. Cloning and expression of genes involved in conidiation and surface properties of Penicillium camemberti grown in liquid and solid cultures. Res. Microbiol. 2008, 159, 110–117. [Google Scholar] [CrossRef]
- Zheng, L.; Campbell, M.; Murphy, J.; Lam, S.; Xu, J.-R. The BMP1 gene is essential for pathogenicity in the gray mold fungus Botrytis cinerea. Mol. Plant-Microbe Interact. 2000, 13, 724–732. [Google Scholar] [CrossRef] [PubMed]
- Takano, Y.; Kikuchi, T.; Kubo, Y.; Hamer, J.E.; Mise, K.; Furusawa, I. The Colletotrichum lagenarium MAP kinase gene CMK1 regulates diverse aspects of fungal pathogenesis. Mol. Plant-Microbe Interact. 2000, 13, 374–383. [Google Scholar] [CrossRef] [PubMed]
- Wang, W.; Liang, X.; Zhang, R.; Gleason, M.L.; Sun, G.Y. Liquid shake culture overcomes solid plate culture in inducing conidial production of Colletotrichum isolates. Australas. Plant Pathol. 2017, 46, 285–287. [Google Scholar] [CrossRef]
- Sakulkoo, W.; Oses-Ruiz, M.; Oliveira Garcia, E.; Soanes, D.M.; Littlejohn, G.R.; Hacker, C.; Correia, A.; Valent, B.; Talbot, N.J. A single fungal MAP kinase controls plant cell-to-cell invasion by the rice blast fungus. Science 2018, 359, 1399–1403. [Google Scholar] [CrossRef]
- Skamnioti, P.; Gurr, S.J. Cutinase and hydrophobin interplay: A herald for pathogenesis? Plant Signal. Behav. 2008, 3, 248–250. [Google Scholar] [CrossRef] [PubMed][Green Version]
- Wang, Y.; Chen, J.; Li, D.-W.; Zheng, L.; Huang, J. CglCUT1 gene required for cutinase activity and pathogenicity of Colletotrichum gloeosporioides causing anthracnose of Camellia oleifera. Eur. J. Plant Pathol. 2017, 147, 103–114. [Google Scholar] [CrossRef]
- Shin, J.H.; Gumilang, A.; Kim, M.J.; Han, J.H.; Kim, K.S. A PAS-containing histidine kinase is required for conidiation, Appressorium formation, and disease development in the rice blast fungus, Magnaporthe oryzae. Mycobiology 2019, 47, 473–482. [Google Scholar] [CrossRef] [PubMed]

| Strains | Growth Rate (mm/d) 1 | Conidiation (105/mL) 2 | Disease Diameter (mm) 3 | |
|---|---|---|---|---|
| Leaf | Fruit | |||
| NC40 (WT) | 6.1 ± 0.1 a | 3.2 ± 0.6 a | 12.2 ± 2.1 a | 35.4 ± 3.0 a |
| ΔCfmk1-23 | 5.9 ± 0.1 a | 3.7 ± 0.8 a | 1.5 ± 0.5 b | 7.2 ± 4.8 b |
| ΔCfmk1-30 | 5.9 ± 0.0 a | 3.3 ± 0.7 a | 1.4 ± 0.6 b | 8.0 ± 6.0 b |
| ΔCfmk1/CfMK1 | 6.2 ± 0.1 a | 3.2 ± 0.5 a | 13.2 ± 1.5 a | 34.8 ± 3.5 a |
Publisher’s Note: MDPI stays neutral with regard to jurisdictional claims in published maps and institutional affiliations. |
© 2022 by the authors. Licensee MDPI, Basel, Switzerland. This article is an open access article distributed under the terms and conditions of the Creative Commons Attribution (CC BY) license (https://creativecommons.org/licenses/by/4.0/).
Share and Cite
Li, C.; Sun, W.; Cao, S.; Hou, R.; Li, X.; Ming, L.; Kan, J.; Zhao, Y.; Liu, F. The CfMK1 Gene Regulates Reproduction, Appressorium Formation, and Pathogenesis in a Pear Anthracnose-Causing Fungus. J. Fungi 2022, 8, 77. https://doi.org/10.3390/jof8010077
Li C, Sun W, Cao S, Hou R, Li X, Ming L, Kan J, Zhao Y, Liu F. The CfMK1 Gene Regulates Reproduction, Appressorium Formation, and Pathogenesis in a Pear Anthracnose-Causing Fungus. Journal of Fungi. 2022; 8(1):77. https://doi.org/10.3390/jof8010077
Chicago/Turabian StyleLi, Chaohui, Weibo Sun, Shulin Cao, Rongxian Hou, Xiaogang Li, Liang Ming, Jialiang Kan, Yancun Zhao, and Fengquan Liu. 2022. "The CfMK1 Gene Regulates Reproduction, Appressorium Formation, and Pathogenesis in a Pear Anthracnose-Causing Fungus" Journal of Fungi 8, no. 1: 77. https://doi.org/10.3390/jof8010077
APA StyleLi, C., Sun, W., Cao, S., Hou, R., Li, X., Ming, L., Kan, J., Zhao, Y., & Liu, F. (2022). The CfMK1 Gene Regulates Reproduction, Appressorium Formation, and Pathogenesis in a Pear Anthracnose-Causing Fungus. Journal of Fungi, 8(1), 77. https://doi.org/10.3390/jof8010077






